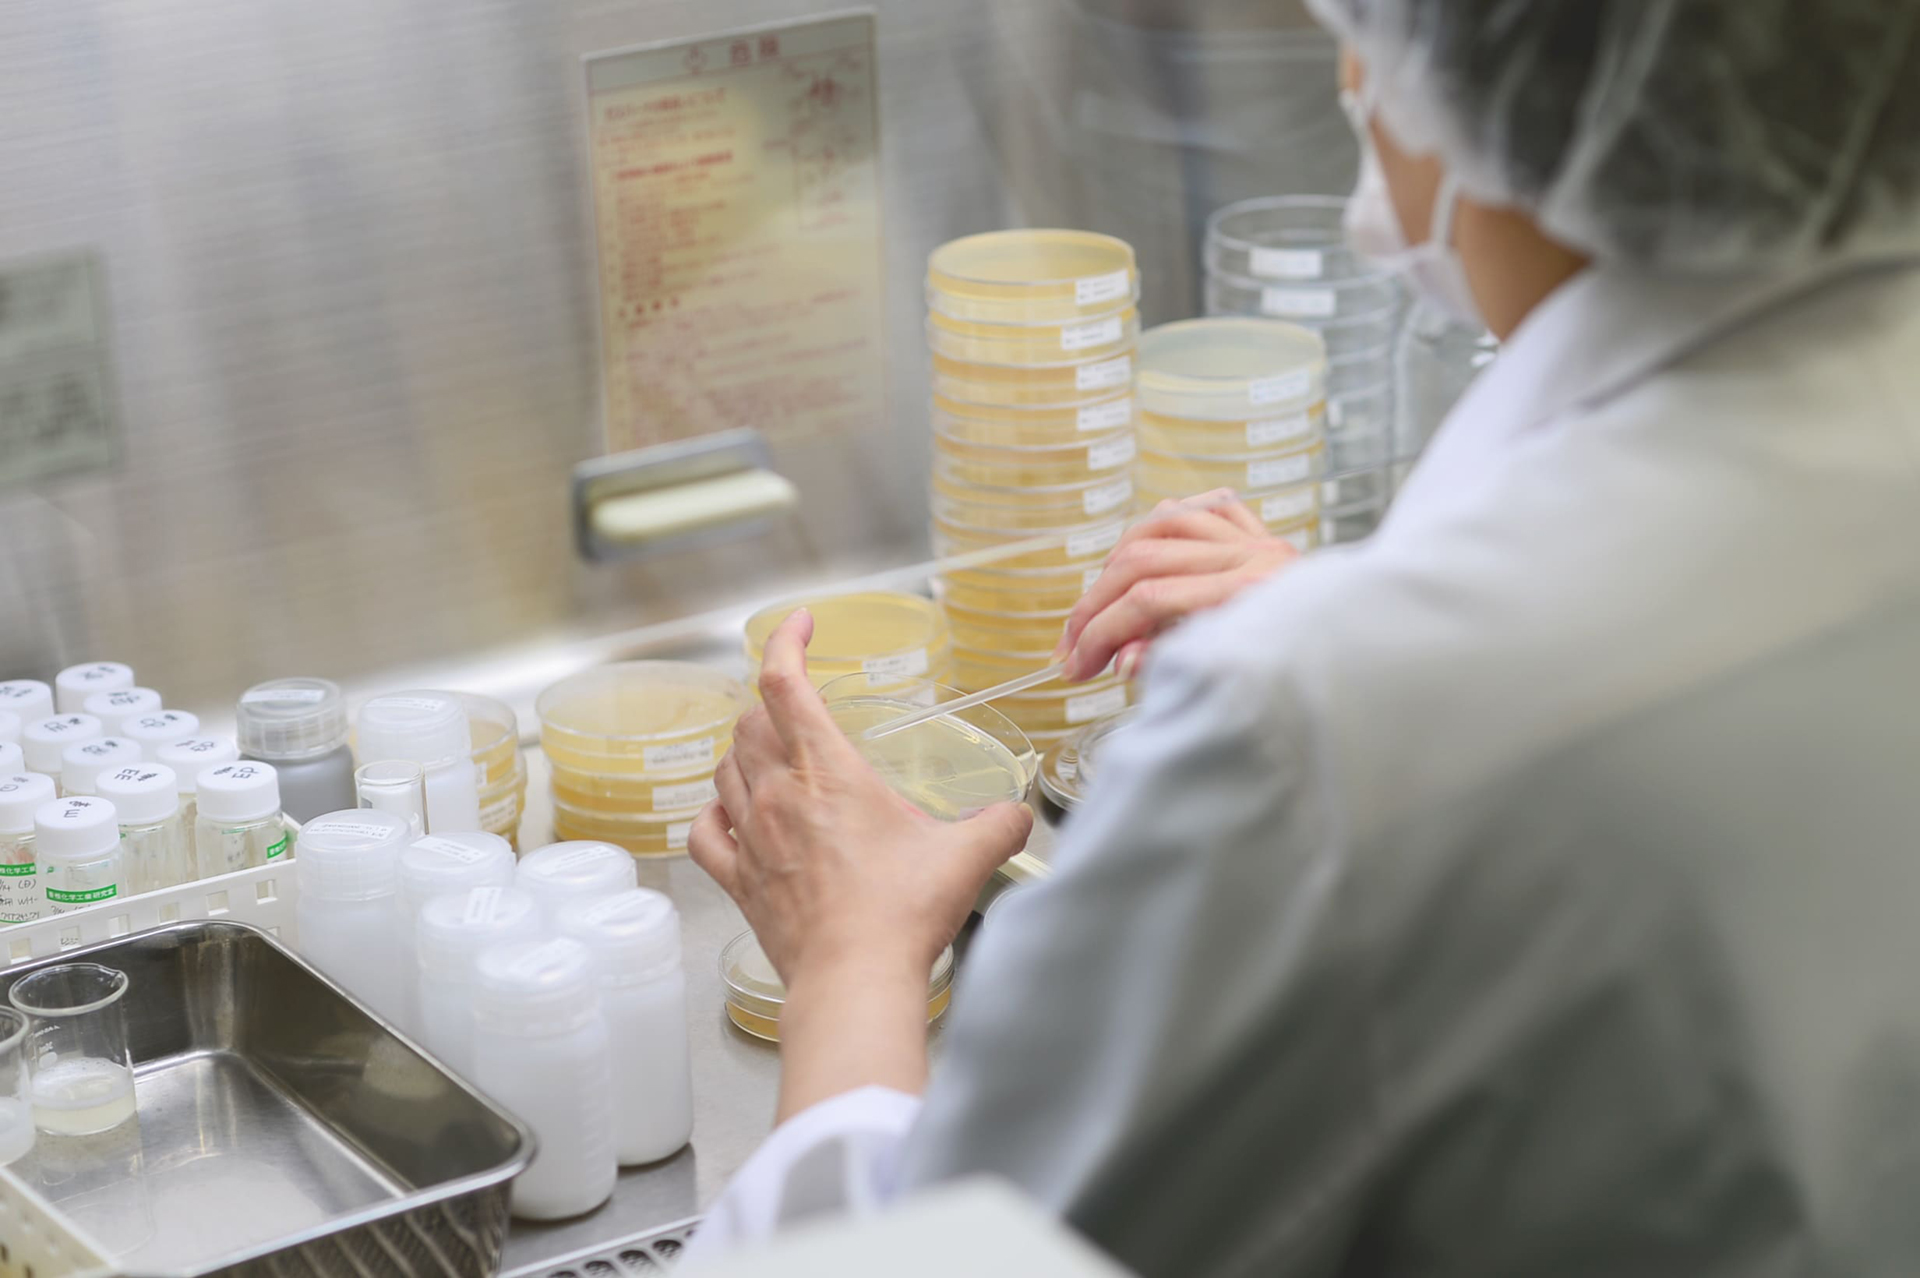

令和6年8月27日発行
第235号
毎月恒例のプレゼントコーナーもあるので最後まで読んで下さいね!
香椎化学工業株式会社
今月のいれもん通信でご紹介するのは、香椎化学工業株式会社です。
香椎化学工業株式会社は、大阪市で美しい素肌の実現を目指したスキンケアをはじめとした化粧品全般の開発・製造・販売を行っている会社で、本社は大阪市ですが、カシーテクニカルセンターが津田サイエンスヒルズというところにあり、アクテックから車で15分ほどで行ける距離にあります。
同じ製造業でも取り扱っているものが全く違うため、工場見学をさせていただいて、原材料の管理はもちろんのことですが、それぞれの工程での衛生管理も徹底しておられ、製品の品質の高さも納得できる工場でした。
昨年から始まった、枚方市のオープンファクトリーイベントである不器用ファクトリーにもアクテックと一緒に参加しており、イベント日には工場見学をすることも可能です。
そんな縁もあり、今回のご依頼となりました。
調合器具ケース
オープンファクトリーなどのワークショップのイベントとして、化粧品の製造体験をされることがあり、その為の機材を段ボールなどに入れて持ち運んでいたそうです。
ビーカーや秤、ゴムへらなど理科の実験で使ったような調合器具を使われており、ビーカーなどはガラスでできているため、持ち運びする時に割れることに気をつけながら持ち運んでいたそうです。
そこで、持ち運ぶのに神経を使わなくてもいい専用のケースがないかという事で、不器用ファクトリーに一緒に参加していた弊社にお声がけ頂きました。
収納物を一つ一つ丁寧に採寸。なるべくケースが小さくなるように、収納物が美しく並ぶように、使いやすいようにレイアウトを試行錯誤しました。
秤や温度計などは、取り出す際の指を入れるスリットを入れているため、内装材にすっぽり入るように設計しましたが、ビーカーは取り出しやすくするために内装材から少し飛び出している仕様にしました。その為、フタ側の波ウレタンも段差を設け、適度な抑え心地で持ち運べるようにしました。
サンプル品やサンプル機材の持ち運びをされる方も多いと思います。専用のケースが欲しいとなればアクテックに是非お問合せ下さい。
展示会来場の御礼
7月24日(水)~26日(金)に東京ビッグサイトで開催されたメンテナンス・レジリエンス TOKYO 2024に出展しました。沢山の方に足を運んでいただきました。本当にありがとうございました。
プレゼントコーナー
豪華プレゼントが当たります
今月は抽選で3名様にプレゼント!!
カシー ボザール マニュアン UVプラス
素肌思いの、家族みんなで使える日やけ止めクリーム 40g 1本
[SPF26 PA+++]
[顔・からだ用]
[ノンケミカル]
[石けんで落とせる]
応募要項
- 応募期間
- 2024年08月27日〜2024年09月03日まで
- 応募対象
- 毎月いれもん通信を購読していただいている方
- 応募方法
- 下記のボタンをクリックして、プレゼント応募フォームで必須事項をご記入いただき「確認する」ボタンを押して下さい。確認画面が表示されますので、記入ミスがないかをご確認の上、「送信」ボタンを押して下さい。
- 当選発表
- 当選者は次号のいれもん通信にて発表させていただきます。
- 大阪府大阪市 S様
- 大阪府大阪市 N様
- 大阪府大阪市 K様
前回もプレゼントにたくさんのご応募をいただきまして、誠にありがとうございました。厳正な抽選によって、上記の方が当選されました。抽選でハズレた方は、今回のプレゼントに期待しててくださいね!
前回もプレゼントにたくさんのご応募をいただきまして、誠にありがとうございました。厳正な抽選によって、上記の方が当選されました。抽選でハズレた方は、今回のプレゼントに期待しててくださいね!